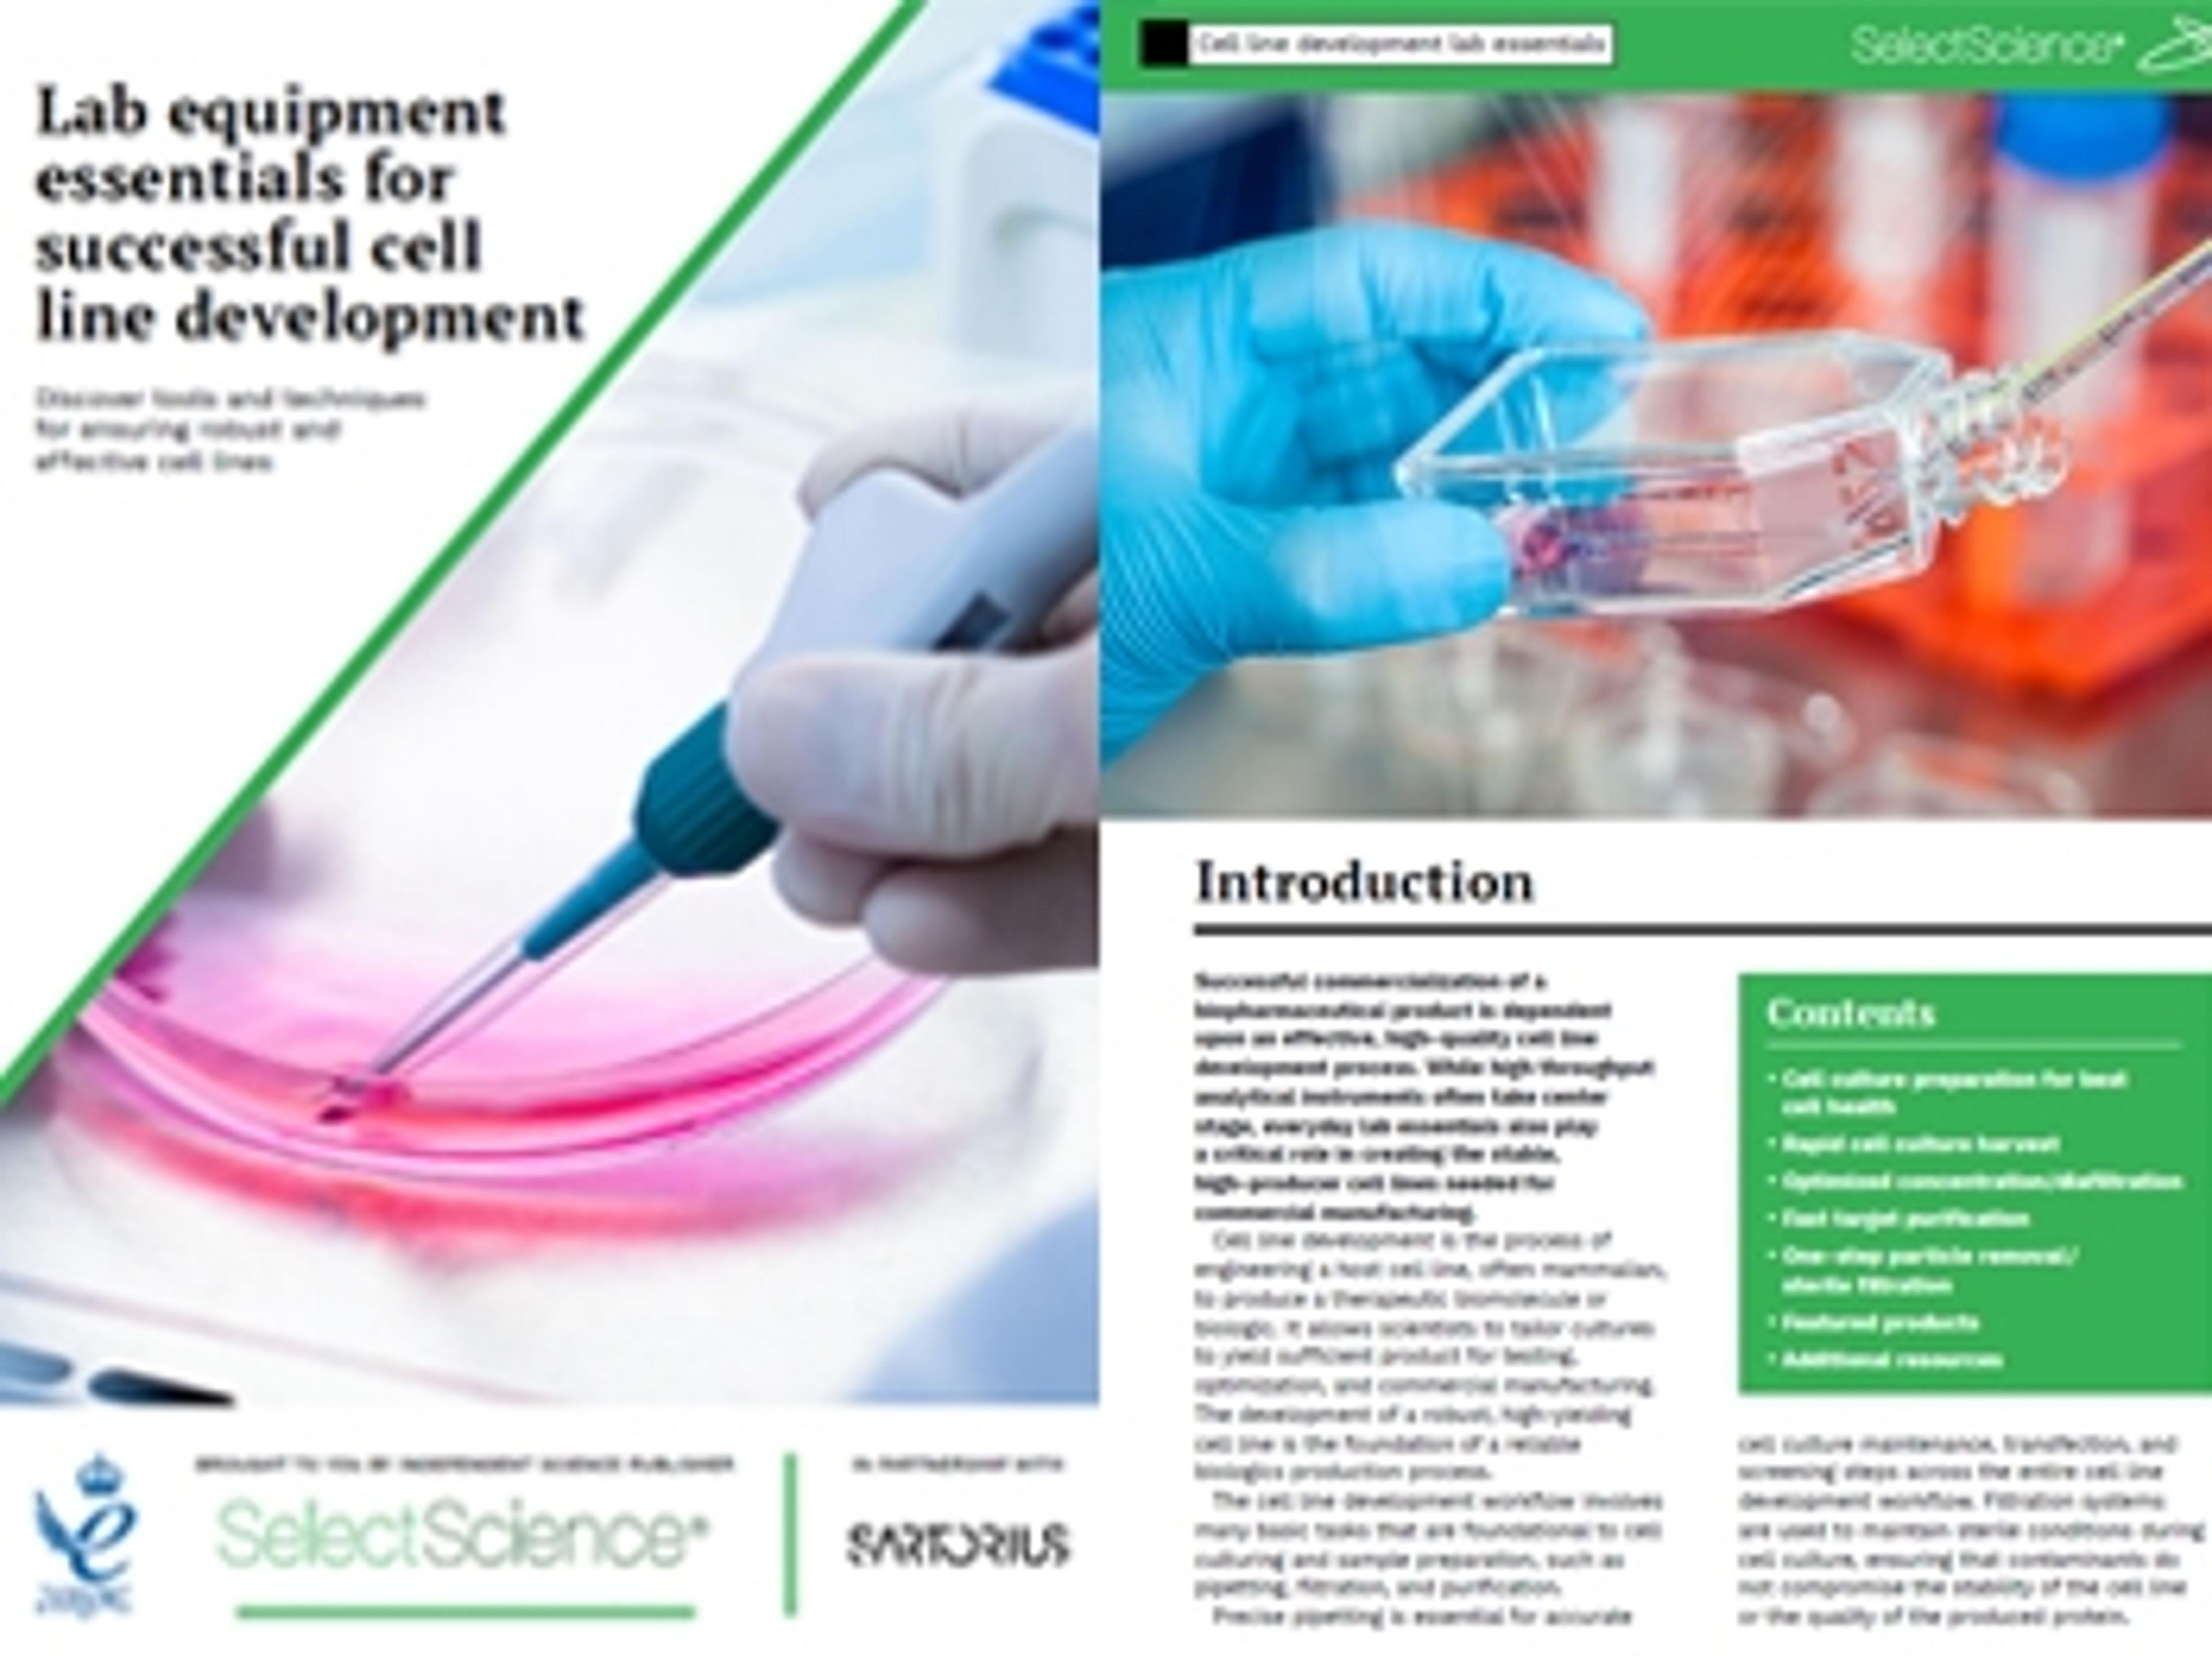

Resources
Selected Filters:
10 challenges and smart solutions in precision weighing
How to master your weighing workflow for real lab performance
A comprehensive guide to master moisture analysis
Lab equipment essentials for successful cell line development
Achieve lab weighing compliance with ease
Optimize your pipette workflows with the ultimate pipetting handbook
Revolutionizing analytical testing in the cosmetics industry
In this expert guide, we explore a diverse range of analytical instruments, along with their applications within the fields of cosmetic research and development, quality management, product improvement and regulatory testing.
Make a seamless transition to automated liquid handling
The art behind good filtration: How to get the best out of filtration
This application eBook provides detailed advice to help pharmaceutical laboratories avoid common setbacks and produce accurate results. Explore this expert guide on drug dissolution testing, and discover how to choose the best filter for your workflows.
Automating cell line development for biologics: A complete guide
Water quality: Key considerations for sensitive applications
Optimizing cell culture workflows for improved results
Assay workflow optimization: Seven elements for enhanced performance
Liquid handling: A guide to pipetting success
NGS: Best practices for sample homogenization
HPLC, pharma and healthcare: Why water purity matters
Is dated weighing technology holding you back?
Take the strain out of compliance, aseptic techniques and quality control
Ultimate Cell Culture Workflow Compendium
Tips for effective cell culture preparation steps, experimental protocols, and subsequent analysis
Ultimate guide to lab weighing success
A guide to avoid common errors, ensure compliance and achieve weighing excellence
Data integrity: Weighing in a regulated environment
Pharma-compliant lab balance systems for the highest standards in data safety and traceability